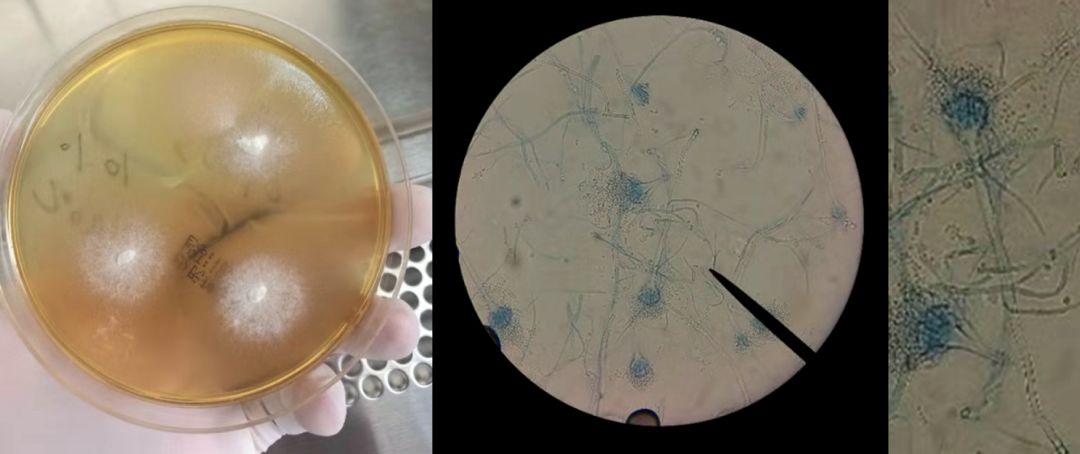
病例分享：无计可施时「黑色的」胸腔积液使治疗找到了方向

编前语
老年男性曾在外院诊断为类风湿性关节炎,近四月来关节疼痛、发热加重,抗结核、抗感染各种治疗多管齐下却效果不佳……经皮胸腔穿刺抽液术抽出黑色胸腔积液!「黑」源于什么?与难诊断的疾病有何关联?病因可能有哪几种?患者的mNGS结果及检验科最终培养结果又回报了什么?
内容来自同济大学附属东方医院举办的第二届「呼吸系统疑难、少见病临床诊治浦江论坛」,现场讨论请戳文末视频观看,或查看以下文字版回顾。
病例回顾
主诉:反复关节疼痛、高热4年,加重4月。
病史摘要
患者老年男性,66 岁,2014年始出现多关节疼痛、间断高热,外院诊断「类风湿性关节炎」,长期口服激素(甲泼尼龙 8mg 1/日)控制病情。近4月来,患者关节疼痛、发热加重,午后为主,体温最高39℃,出现咳嗽、咳白粘痰,伴寒战、发热,活动后稍感胸闷、气急,无明显胸痛、咯血。体重下降明显。外院予以「羟氯喹、雷公藤、阿法骨化醇、激素」治疗后,症状无明显改善。2018年7月19日,痰查抗酸杆菌阳性。予以异烟肼+利福平+乙胺丁醇+左氧氟沙星抗结核治疗,仍有间断高热。为进一步诊治,来我院就诊。既往有有高血压、糖尿病病史,随机血糖波动在10~19mmol/L。
诊治经过
1、入院查体
慢性病容,满月脸,双手指轻度变形,左肺呼吸音偏低,右肺呼吸音粗,两下肺可闻及散在湿性啰音。心律齐,肝脾肋下未触及,双下肢不浮肿,四肢关节疼痛明显。全身淋巴结未触及肿大。
2、辅助检查
血沉 97mm/h↑,CRP 180mg/L↑,PCT 0.21ug/L↑。血常规:WBC 10.41 ×10^9/L↑,N% 75.4%↑,HGB 104.0g/L↓,PLT 188×10^9/L。粪常规:隐血 +++。HIV、HAV-IGM、乙肝两对半、丙肝抗体、RPR试验均阴性。生化:白蛋白26g/L↓,总蛋白55g/L↓。BNPpro 187pg/ml,糖化血红蛋白6.8%↑,D-二聚体 0.346ug/ml↑。IgE 1000.0IU/ml↑,CRP 180.00mg/l↑,抗O<54.1IU/mL,RF 12.6 IU/mL,内毒素鲎定量测定<5pg/ml。真菌D-葡聚糖检测<10pg/ml,
肿瘤指标:CA-125 30.7U/ml↑,余正常。PPD试验一般阳性、TSPOT试验阳性。
心电图:正常心电图;B超:胆囊显示不清,双侧胸腔积液(左侧见深约27mm无回声区,右侧见深约12mm无回声区,胰腺、脾脏、双肾未见明显异常。外院胸部CT(2018-7-19)示:右肺上叶及左肺下叶多发厚壁空洞,右肺上叶及两肺下叶炎症改变。(图1)

图1
3、如何治疗
入院后予以抗结核、抗感染(异烟肼+利福平+乙胺丁醇+吡嗪酰胺+莫西沙星+头孢西丁), 化痰、保肝、降糖、营养支持治疗。体温仍波动在38~39℃,加用哌拉西林他巴唑加强抗感染,体温下降不明显 。
考虑患者每次均发热后关节疼痛明显,不除外「类风湿」控制不佳,先后予以激素加量、丙种球蛋白冲击治疗,效果不佳。2018-08-13 突发急性前间壁心肌梗塞,予以内科保守治疗后平稳。
此后患者仍有发热,调整抗生素为比阿培南+利奈咗胺后加强抗感染治疗,体温仍波动在39℃。复查胸部CT(2018-8-20)示:右肺上叶厚壁空洞,两肺上叶及左肺下叶炎性渗出增多,左下少量胸腔积液(图2)。

图2
为进一步明确诊断,予以予以经皮胸腔穿刺抽液术,可见抽出黑色胸腔积液(图3)。胸腔积液mNGS结果回报:检出聚多曲霉 66个序列数。给予伏立康唑抗真菌治疗,患者咳嗽、咳痰明显好转,体温恢复正常。复查胸部CT(2018-8-25):肺部病灶较前明显好转(图4)。NGS结果回报后,通知检验科针对曲菌更改培养条件、延长培养时间,20多天后最终培养结果回报:聚多曲霉(图5)。患者出院后持续伊曲康唑抗真菌、正规抗结核治疗,未再出现发热,关节疼痛也明显好转,停用非甾体类止痛药和激素,随访中。

图3

图4
图5
补充诊断
侵袭性肺部真菌感染(聚多曲菌)
评述
聚多曲霉(Aspergillus sydowi)又称萨氏曲霉,归入半知菌亚门,丝孢菌纲,丝孢菌目,丛梗孢科,曲霉属,杂色曲霉群。此菌广泛分布于自然界,其可产生杂色曲霉素。动物实验证明聚多曲霉可致肝癌、胃癌,研究证实其产物对肿瘤细胞有双向调节作用。文献报道本菌可引起外耳道曲霉病、阻塞性支气管曲霉病 [1-2],但发生侵袭性肺部真菌感染导致胸腔积液未见报道,可能与该患者长期使用激素和免疫*制剂抑**有关。目前认为伊曲康唑治疗曲霉感染疗效是肯定的。
临床中可引起黑色胸腔积液的病因主要有以下几种:
1、感染,如黑曲霉、米根霉等;
2、含黑色物质的肿瘤细胞,如黑色素瘤;
3、出血或溶血,常见于肺癌和胰腺假性囊肿破裂;
4、含痰脓胸,如大量吸入活性炭 [3]。实际上真菌感染引起的黑色胸腔积液不仅只有黑曲霉、米根霉,包括聚多曲霉、土曲霉等在内的杂色曲霉的感染均有可能。多数黑色胸腔积液是胸腔内大量出血后的溶血及携带含铁血黄素的巨噬细胞引起的 [4-5]。
该患者存在免疫缺陷,胸腔积液中mNGS和培养均证实聚多曲霉菌感染,抗真菌治疗后病灶持续吸收,故IPFI诊断明确。但辅助检查可见高IgE,且肺内病灶的吸收迅速,有无ABPA可能值得探讨 [6]。
参考文献
[1] 廖万清, 温海, 陈裕充,李强 等. 首例报告聚多曲霉引起的阻塞性支气管曲霉病[J]. 中国皮肤性病学杂志, 2003, 17(2):93-94.
[2] 赖红琳, 李强. 聚多曲霉菌提取液对培养人肺鳞癌细胞增殖的影响[J]. 第二军医大学学报, 2005, 26(11):1325-1326.
[3] Jayakrishnan B,et al. Black pleural effusion[J].Lancet. 2015,386 ( 9995 ): e7
[4] Cole, Randolph P . Black Pleural Effusion[J]. The American Journal of Medicine, 2013, 126(12):e19.
[5] Thampy E , Cherian S V . Black pleural effusion[J]. Qjm Monthly Journal of the Association of Physicians, 2016.
[6] 中华医学会呼吸病学分会哮喘学组. 变应性支气管肺曲霉病诊治专家共识[J]. 中华医学杂志, 2017, 97(34).]
专家介绍

来源:第二届「呼吸系统疑难、少见病临床诊治浦江论坛」
病例提供:解放军第905医院肺科
病例整理:王银珍、方柄、周计雪、刘世家、夏凡、吴晓东